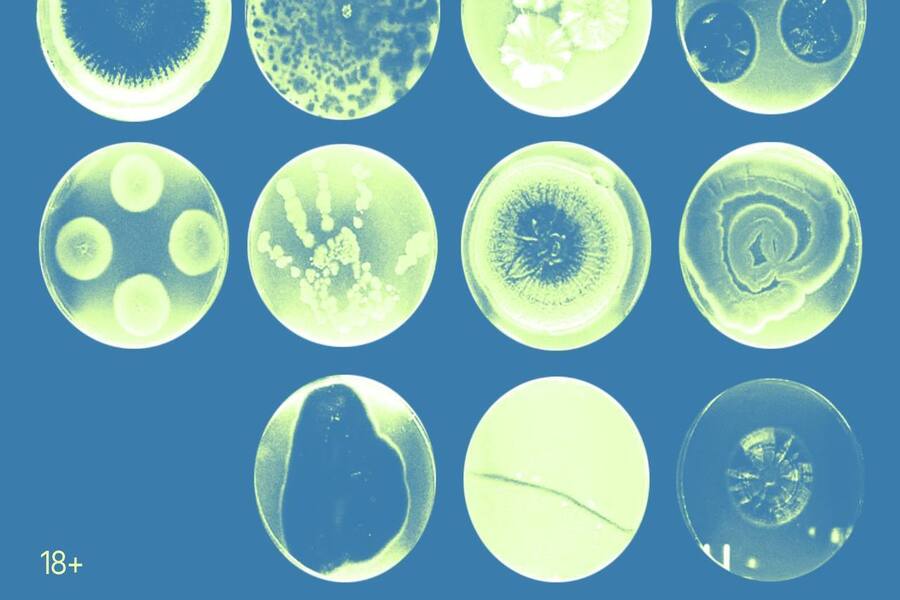
В Калининграде пройдёт лекция «Собирать живое и жизнеподобное»

В Калининграде пройдёт лекция «Собирать живое и жизнеподобное»
29 октября 2025, 15:57
Дом китобоя приглашает в среду, 5 ноября, на лекцию художника и куратора Дмитрия Булатова «Собирать живое и жизнеподобное» (18+). Встреча будет посвящена вопросам коллекционирования произведений Art&Science и технологического искусства, где художественные практики тесно связаны с робототехникой, IT и биомедициной. Информация об этом размещена в телеграм-канале учреждения.
Лектор расскажет, как музеи и частные собрания формируют новые правила, сталкиваясь с работами, в которых медиумом выступают живые ткани, автономные алгоритмы и кибернетические устройства. Коллекционирование здесь выходит за рамки «хранения артефактов» — оно требует понимания биологических процессов, поддержания технических систем и научного сопровождения. На примерах ряда международных проектов на встрече также обсудят стратегии,позволяющие интегрировать такие произведения в музейные и институциональные структуры, сохраняя их художественный и исследовательский потенциал.
Начало запланировано на 18:30. Вход — 300 руб.
Подписывайтесь на наш новый Телеграм-канал по ссылке!




